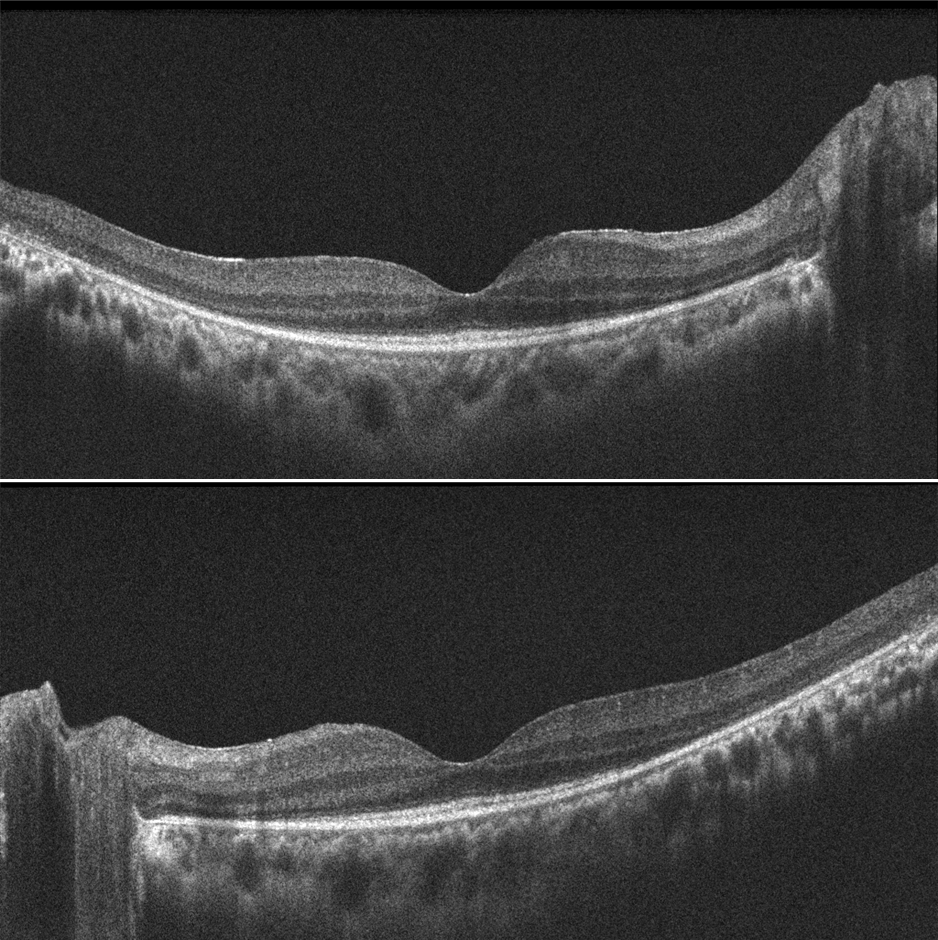

A 26-year-old female patient with cystoid macular edema (CME) secondary to retinitis pigmentosa (RP). Pretreatment OCTs show CME bilaterally. After one month of topical Brinzolamide treatment, visual acuity improved from 20/50 to 20/30 and CME resolved bilaterally.
Cystoid macular edema can complicate retinitis pigmentosa and has been reported to occur in 10-50% of patients. The underlying pathogenesis of RP-associated CME (RP-CME) remains unclear, but several mechanisms have been proposed, including disruption of the blood-retinal barrier, failure of the pumping mechanism in the retinal pigment epithelium, Müller cell edema and dysfunction, antiretinal antibodies, and vitreous traction. Limited data are available regarding the effectiveness of RP-CME treatments. Treatments tried to date include oral and topical carbonic anhydrase inhibitors (CAIs), oral, topical, intravitreal and periocular steroids, topical non-steroidal anti-inflammatory drugs, photocoagulation, vitrectomy with internal limiting membrane peeling, oral lutein, and intravitreal antivascular endothelial growth factor injections. Currently, available evidence suggests that topical CAIs can be used as a first-line approach. The possibility of side effects and the rebound potential of CME must be considered. Oral CAIs may be a second-line agent, but there is a greater risk of side effects.
Credit: M. Giray Ersoz, MD, FEBO
Biruni University School of Medicine, Department of Ophthalmology, Istanbul, Turkey
Instagram accounts: @retina.review and @retina.dr.girayersoz